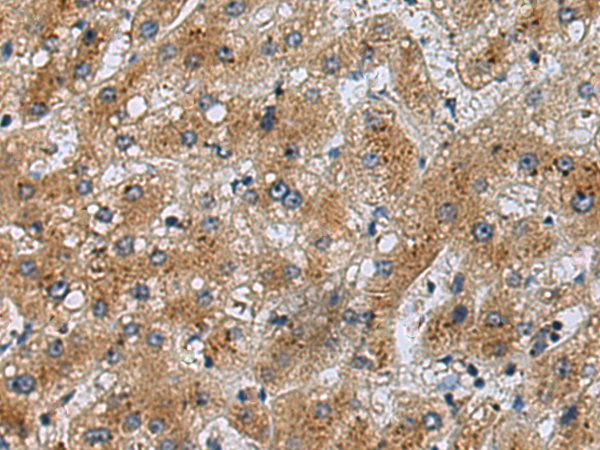

|
Background: |
Lysophospholipases are enzymes that act on biological membranes to regulate the multifunctional lysophospholipids. There are alternatively spliced transcript variants described for this gene but the full length nature is not known yet. |
|
Applications: |
ELISA, IHC |
|
Name of antibody: |
LYPLA2 |
|
Immunogen: |
Full length fusion protein |
|
Full name: |
lysophospholipase II |
|
Synonyms: |
APT2; APT-2; DJ886K2.4 |
|
SwissProt: |
O95372 |
|
ELISA Recommended dilution: |
5000-10000 |
|
IHC positive control: |
Human lung cancer |
|
IHC Recommend dilution: |
25-100 |

購物車
幫助
021-54845833/15800441009
